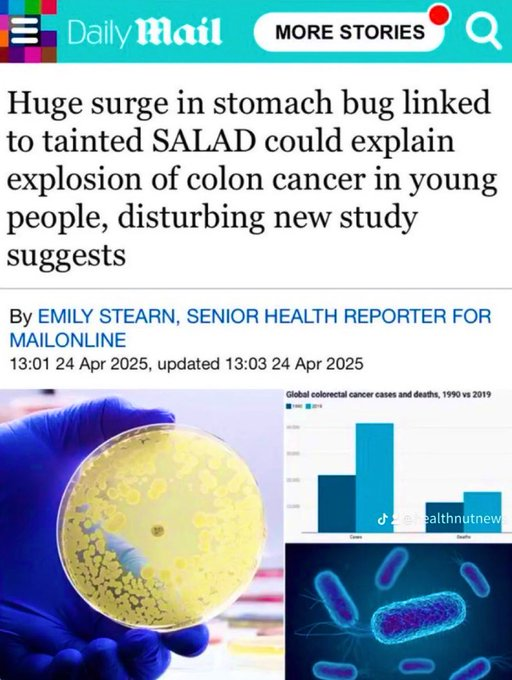
image.png

Question: What is the functional difference between St. Fow Chee and the dazzler?Lab Leak: The True Origins of Covid-19
Nice upgrade to the site
Answer: Fow Chee paid for the creation of the virus. Other than that, nothing.
Question: What is the functional difference between St. Fow Chee and the dazzler?Lab Leak: The True Origins of Covid-19
Nice upgrade to the site

I don't get mad at retards. I just laugh at them. I miss @MelloDawg sharing his "thoughts".Just in case you were planning on possibly not being pissed off on a Sunday:
I don't get mad at retards. I just laugh at them. I miss @MelloDawg sharing his "thoughts".Just in case you were planning on possibly not being pissed off on a Sunday:

Adam Carolla revealed on his show that he was friends with Nicky and he hung himself. Sad

actually it sounds pretty cool when you put it like that. Like buffing in an RPGOccam’s Razor…
Then you have genuinely abhorrent people like @HHusky promoting this for everyone other than themselves.